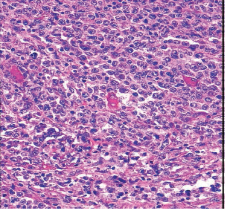

A precisão do diagnóstico anatomopatológico e biológico é um pré-requisito indispensável para o tratamento adequado de um paciente com cancro.
A morfologia, padrão-ouro de qualquer análise inicial: citológica, através da análise microscópica das células, e histológica, através da análise dos tecidos, é agora complementada por uma abordagem multidisciplinar: biológica e genética, de acordo com os critérios da OMS. Estas técnicas dispendiosas ainda não estão totalmente acessíveis aos países de rendimento baixo e médio, agravando as desigualdades no acesso aos cuidados de saúde nesses países.
Várias abordagens estão a ser implementadas na AMCC para melhorar o processo de diagnóstico nesses países, especialmente na África.
A melhoria das técnicas padrão de citologia e anatomia patológica e o acesso à telepatologia.
Atualmente, esta última é realizada através da transmissão pela Internet de imagens microscópicas digitalizadas (imagens jpeg). Estas imagens são selecionadas por citologistas ou anatomopatologistas locais que utilizam um microscópio com uma câmara digital ligada a um computador e a uma plataforma de intercâmbio científico, a plataforma «i-Path», ligada à rede INCTR (International Network for Cancer Treatment and Research). Esta plataforma inclui vários grupos de intercâmbio científico constituídos por médicos identificados (hematologistas, anatomopatologistas, clínicos) em ligação com um grupo de especialistas internacionais nas diferentes áreas do cancro. Estes últimos comentam as imagens, ajudando os intervenientes locais a estabelecer um diagnóstico.
Trata-se de uma rede já em funcionamento que abrange vários centros nos seguintes países:
Senegal, Costa do Marfim, República Democrática do Congo, Camarões, Benim, Madagáscar, Burquina Faso, Mali, Marrocos, Tunísia.

A implementação de técnicas para caracterizaras células:
- Imunohistoquímica em corte.
- A citometria de fluxo.
- A análise dos cromossomas.




A implementação das técnicas complementares necessárias para o diagnóstico é realizada em coordenação com os projetos de tratamento terapêutico do cancro.
Martine RAPHAËL - Aurore COULOMB - Elisabeth AUBERGER